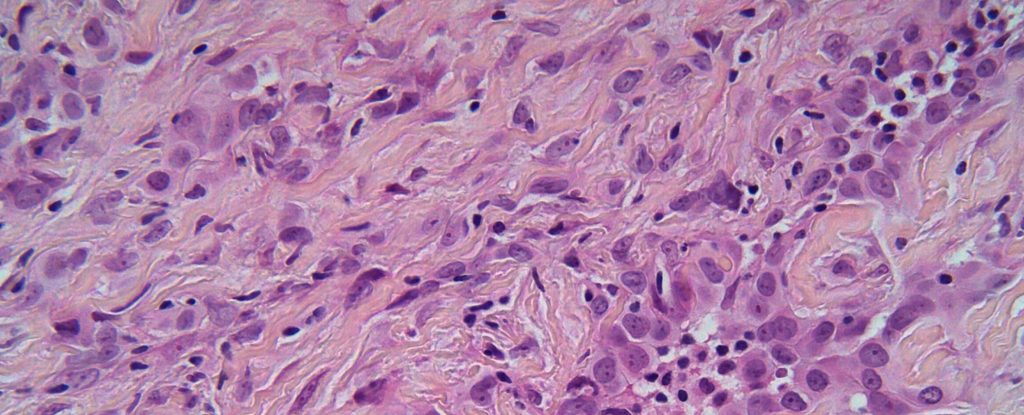

cncpt-artikel_lb_atf
Dobbelt immunterapi forlænger fortsat overlevelsen ved malignt pleural mesotheliom
CheckMate 743-studiet tyder på, at immunterapi-kombinationen nivolumab + ipilimumab er vejen til overlevelse hos patienter med inoperabel malignt pleural mesotheliom.
Brænder du for at skrive?
Vil du gerne dele din forskning eller dine kliniske erfaringer med dine kollegaer inden for netop dit speciale? Har du en ide til en artikel, som du gerne vil udgive hos os? Send redaktionen en mail på redaktion@bpno.dk
Send mail til redaktionen